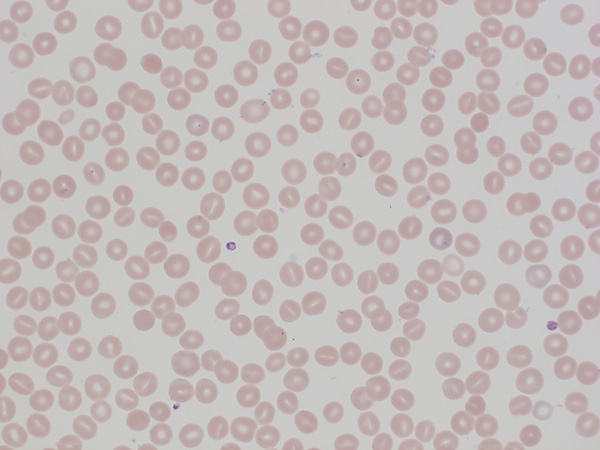

Наследственный стоматоцитоз
Насле́дственный стоматоцито́з (НС) — группа аутосомно-доминантных заболеваний, характеризующихся повышенной проницаемостью мембраны эритроцитов для ионов калия и натрия, что приводит к компенсаторному усилению активного транспорта этих катионов.
Клиническая картина включает гемолитическую анемию средней или тяжёлой степени, спленомегалию у большинства пациентов и частые осложнения в виде жёлчнокаменной болезни. При длительном течении заболевания, особенно у пациентов, получающих многократные трансфузии эритроцитарной массы, может развиваться перегрузка железом. Характерно частое развитие дефицита фолиевой кислоты, который усугубляет гемолиз и тяжесть анемии. В некоторых случаях заболевание осложняется парвовирусной инфекцией с развитием апластического криза. Наследственный ксероцитоз обычно протекает в лёгкой форме, однако описаны случаи с осложнениями в виде самопроизвольных абортов и водянки плода[1].
Общие сведения
История
Наследственный дегидратационный стоматоцитоз был впервые описан в 1971 году, и на основе анализа характера передачи в поражённых семьях была предположена аутосомно-доминантная форма наследования.
В 2012 и 2013 годах три исследовательские группы почти одновременно идентифицировали генетические изменения, связанные с этим заболеванием, обнаружив их в гене PIEZO1[2].
Классификация
Наследственные стоматоцитозы классифицируются по фенотипу и подразделяются на гипергидратированный и дегидратированный типы, которые могут быть дополнительно дифференцированы в зависимости от температурной зависимости утечки катионов[3].
Гематологи идентифицировали ряд вариантов наследственного стоматоцитоза, которые классифицируются следующим образом[4]:
- гипергидратированный наследственный стоматоцитоз;
- дегидратированный наследственный стоматоцитоз;
- дегидратированный наследственный стоматоцитоз с перинатальным отёком и/или псевдогиперкалиемией;
- криогидроцитоз;
- вариант Блэкберн;
- семейная псевдогиперкалиемия (не ассоциированная с гемолитической анемией).
Этиология
НС развивается вследствие мутаций в генах, кодирующих ключевые белки, регулирующие ионный транспорт и осмотический баланс эритроцитов. Ген PIEZO1 кодирует одноимённый катионный канал, мутации которого приводят к его гиперактивации и избыточной потере калия и воды. Ген ABCB6 кодирует белок — АТФ-связывающий кассетный транспортёр субсемейства B, участвующий в переносе порфиринов; его мутации усиливают проницаемость мембраны для катионов. Ген KCNN4 кодирует кальций-зависимый калиевый канал (канал Гардоша), мутации в котором вызывают нарушение регуляции объёма эритроцитов. Ген RHAG кодирует Rh-ассоциированный гликопротеин, функционирующий как переносчик аммония и углекислого газа; его мутации расширяют ионный канал, усиливая утечку катионов. Ген SLC4A1 кодирует белок полосы 3, мутации которого преобразуют его в неселективный катионный канал. Ген SLC2A1 кодирует переносчик глюкозы GLUT1, мутации которого нарушают транспорт глюкозы и повышают проницаемость для катионов. Гены ABCG5 и ABCG8 кодируют соответственно стеролин-1 и стеролин-2, которые формируют гетеродимерный транспортёр стеролов; их мутации нарушают липидный состав мембраны. Все эти дефекты объединяет общий механизм: нарушение ионного гомеостаза приводит к обезвоживанию эритроцитов, изменению их формы на стоматоцитарную и преждевременному гемолизу. Однако в группу НС также входят и гипергидратированные с увеличенным объёмом эритроцитов за счет накопления воды внутри клеток[4].
Патогенез
Продолжительность жизни эритроцитов определяется их гидратацией, объёмом и эластичностью, особенно при прохождении через синусоиды селезёнки и капилляры. Эти свойства обеспечиваются целостностью и нормальным функционированием мембраны. Критическую роль в поддержании гидратации играет баланс внутриклеточных катионов (натрия и калия), который регулируется за счёт активного ATФ-зависимого транспорта и диффузии через ионные каналы. Поскольку движение воды следует за ионами, нарушение регуляции катионного потока приводит к изменению гидратации эритроцитов[2].
При дегидратационном НС дефект мембранных белков вызывает утечку калия из эритроцитов, которая превышает поступление натрия. Это приводит к чистой потере воды, обезвоживанию, сморщиванию клеток, повышению их хрупкости и гемолизу. В большинстве случаев молекулярной основой заболевания являются мутации в гене PIEZO1, кодирующем механочувствительный катионный канал. Эти мутации приводят к эффекту усиления функции — замедленной инактивации канала. При прохождении через капилляры механическое воздействие активирует мутантный канал PIEZO1, что вызывает повышенное поступление кальция в клетку. Это, в свою очередь, активирует кальций-зависимый калиевый канал Гардоша (кодируется геном KCNN4), что усиливает выход калия и усугубляет потерю жидкости. Реже аналогичный фенотип развивается из-за мутаций в гене KCNN4, которые также приводят к гиперактивации канала Гардоша и усиленной потере калия. Обезвоженные эритроциты теряют способность к деформации, становятся уязвимыми к разрушению в селезёнке, и их продолжительность жизни сокращается[2].
Гипергидратированный НС характеризуется повышенной проницаемостью мембраны эритроцитов для моновалентных катионов, что связано с отсутствием белка стоматина. Это приводит к избыточному поступлению катионов и воды в клетку, приводя к формированию крупных, осмотически нестабильных эритроцитов со сниженной средней концентрацией гемоглобина. Основным генетическим дефектом при данном варианте являются мутации в гене RHAG, кодирующем Rh-ассоциированный гликопротеин. В более лёгких случаях заболевания также идентифицируются мутации в гене SLC4A1, кодирующем белок полосы 3. Эти мутации нарушают нормальный ионный транспорт, что приводит к характерному для заболевания нарушению гидратации эритроцитов[4].
Эпидемиология
Распространённость НС обычно оценивается как 1:2000, в то время как оценки для дегидратационного НС варьируются от 1:10 000 до 1:50 000. Оценки распространённости могут быть неточными из-за недостаточной диагностики и отсутствия системных популяционных исследований. Исследование, анализировавшее показатели общего анализа крови 48 миллионов пациентов Северной Америки, показало, что до 1:8000 человек потенциально могут иметь дегидратационный НС[5].
Диагностика
Клиническая картина НС характеризуется развитием гемолитической анемии средней или тяжёлой степени. У большинства пациентов наблюдается спленомегалия и жёлчнокаменная болезнь. При длительном течении заболевания, особенно на фоне многократных гемотрансфузий, развивается перегрузка железом. Характерным признаком является частый дефицит фолиевой кислоты, который усугубляет течение гемолиза и усиливает выраженность анемии. В некоторых случаях заболевание осложняется парвовирусной инфекцией с развитием апластического криза[1].
- Клинический анализ крови: характерно повышение среднего объёма эритроцита при снижении средней концентрации гемоглобина в эритроците[1].
- Биохимический анализ крови: характерно повышение концентрации непрямого билирубина[1].
- Микроскопия мазка крови: характерно изменение формы эритроцитов по типу чаши[1].
- Измерение осмотической хрупкости.
- Оценка утечки катионов.
- Осмотические кривые.
- Обязательное молекулярно-генетическое подтверждение.
Дифференциальная диагностика
Лечение
Лечение НС включает несколько направлений. Спленэктомия позволяет уменьшить выраженность гемолиза, хотя и не обеспечивает его полного устранения. При развитии анемии с уровнем гемоглобина ниже 65 г/л показано проведение трансфузий эритроцитарной массы. Для пациентов с НС характерен дефицит фолиевой кислоты, требующий обязательной коррекции. В случаях многократных гемотрансфузий может потребоваться назначение хелаторной терапии для предотвращения перегрузки железом[1].
Прогноз
Прогноз при НС благоприятный[1].
Диспансерное наблюдение
Не разработано.
Профилактика
Не разработана.
Примечания
- ↑ 1 2 3 4 5 6 7 8 Романенко Н. А. Наследственные гемолитические анемии. Мембранопатии (лекция). Часть 1 // Вестник гематологии. — 2022. — № 1.
- ↑ 1 2 3 Frederiksen H. Dehydrated hereditary stomatocytosis: clinical perspectives (англ.) // Journal of Blood Medicine. — 2019. — 4 July (vol. 10). — P. 183—191. — doi:10.2147/JBM.S179764.
- ↑ Flatt J.F., Bruce L.J. The hereditary stomatocytoses (англ.) // Haematologica. — 2009. — August (vol. 94, no. 8). — P. 1039—1041. — doi:10.3324/haematol.2009.010041.
- ↑ 1 2 3 Andolfo I., Russo R., Gambale A., Iolascon A. Hereditary stomatocytosis: An underdiagnosed condition (англ.) // American Journal of Hematology. — 2018. — January (vol. 93, no. 1). — P. 107—121. — doi:10.1002/ajh.24929.
- ↑ Mottelson M., Helby J., Petersen J. et al. Hereditary stomatocytosis in the general population: A genetically based prevalence estimate from a 109,039 individual Danish cohort (англ.) // American Journal of Hematology. — 2025. — January (vol. 100, no. 1). — P. 152—157. — doi:10.1002/ajh.27508.
- ↑ S.K. Jha, S. Vaqar. Hereditary Elliptocytosis (англ.). Statpearls (26 февраля 2024). Дата обращения: 19 сентября 2025.
Литература
- Романенко Н. А. Наследственные гемолитические анемии. Мембранопатии (лекция). Часть 1 // Вестник гематологии. — 2022. — № 1.
- Flatt J.F., Bruce L.J. The hereditary stomatocytoses (англ.) // Haematologica. — 2009. — August (vol. 94, no. 8). — P. 1039—1041. — doi:10.3324/haematol.2009.010041.
- Frederiksen H. Dehydrated hereditary stomatocytosis: clinical perspectives (англ.) // Journal of Blood Medicine. — 2019. — 4 July (vol. 10). — P. 183—191. — doi:10.2147/JBM.S179764.